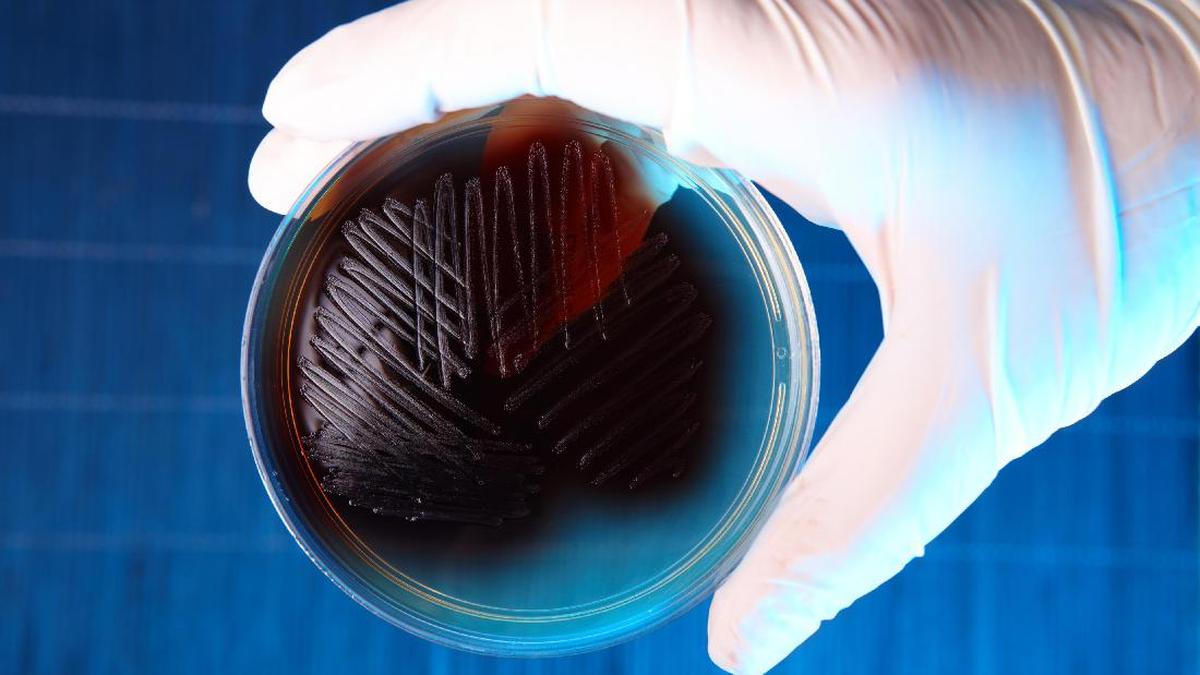

Jakarta –
Kepala Badan Pengawas Terapi dan Minuman (BPOM RI) Prof Taruna Ikrar menekankan sudah 45 persen antibiotik yang ada Ke Indonesia kebal Di bakteri Escherichia coli. Bakteri yang kerap ditulis E coli ini adalah bakteri yang biasa hidup Ke usus manusia dan hewan, yang fungsinya menjaga Kesejaganan sistem pencernaan.
Akan Tetapi, ada jenis E coli tertentu yang dapat menyebabkan Penyakit Menyebar Supaya menimbulkan Tanda-Tanda diare, sakit perut, dan kram. Jenis bakteri E coli berbahaya ini menghasilkan toksin Shiga (STEC). Ini adalah sejenis racun yang dapat menyebabkan Gangguan bawaan Minuman yang parah.
Racun Di bakteri E coli tersebut dapat menular Ke manusia Melewati konsumsi Minuman yang terkontaminasi. Seperti daging mentah atau setengah mata, susu mentah, dan sayuran mentah yang terkontaminasi.
ADVERTISEMENT
SCROLL TO CONTINUE WITH CONTENT
“Kita sudah ada 45 persen antibiotik kita resisten Di Escherichia coli. Dan kita tahu itu salah satu bakteri yang lazim Ke Negeri kita. Nah bisa dibayangin kalau ini berdampak Ke orang yang menderita,” tuturnya Di ditemui Ke kawasan Cakung, Jumat (2/5/2025).
“Seperti ini dikasih antibiotik tidak sembuh-sembuh. Dari Sebab Itu dia bisa meninggal hanya Sebab sebetulnya Gangguan biasa. Dari Sebab Itu kita mau cegah resistensi antibiotik ini supaya tidak terjadi silent pandemic.”
(naf/kna)
Artikel ini disadur –> Detik.com Indonesia Berita News: Bakteri Ini Makin Kebal! 45 Persen Antibiotik Ke Indonesia Tak Bisa Membunuhnya